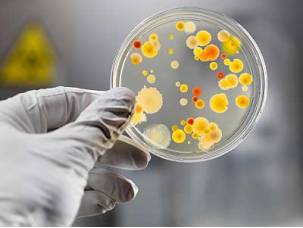

Esse vírus é o principal fator associado aos cânceres de útero, da vulva, da vagina e do ânus
Uma nova vacina aprovada pela Anvisa na terça-feira, 26, ampliou a proteção contra o papilomavírus humano (HPV). O novo medicamento é o Gardasil 9, que inclui cinco novos subtipos na proteção com a doença. Esse vírus é o principal fator associado aos cânceres de útero, da vulva, da vagina e do ânus.
O Gardasil 9 foi aprovado com indicação para pessoas de 9 a 26 anos, do sexo masculino e feminino. O ideal é que a imunização seja feita antes do início da vida sexual. Mais da metade da população brasileira jovem, de 16 a 25 anos, tem HPV, segundo estimativa de um estudo do Hospital Moinhos de Vento, de Porto Alegre, e do Ministério da Saúde. As informações são do jornal O Estado de S. Paulo.
O Gardasil 9 foi aprovado com indicação para pessoas de 9 a 26 anos, do sexo masculino e feminino. O ideal é que a imunização seja feita antes do início da vida sexual. Mais da metade da população brasileira jovem, de 16 a 25 anos, tem HPV, segundo estimativa de um estudo do Hospital Moinhos de Vento, de Porto Alegre, e do Ministério da Saúde. As informações são do jornal O Estado de S. Paulo.
FONTES: CORREIO 24HORAS